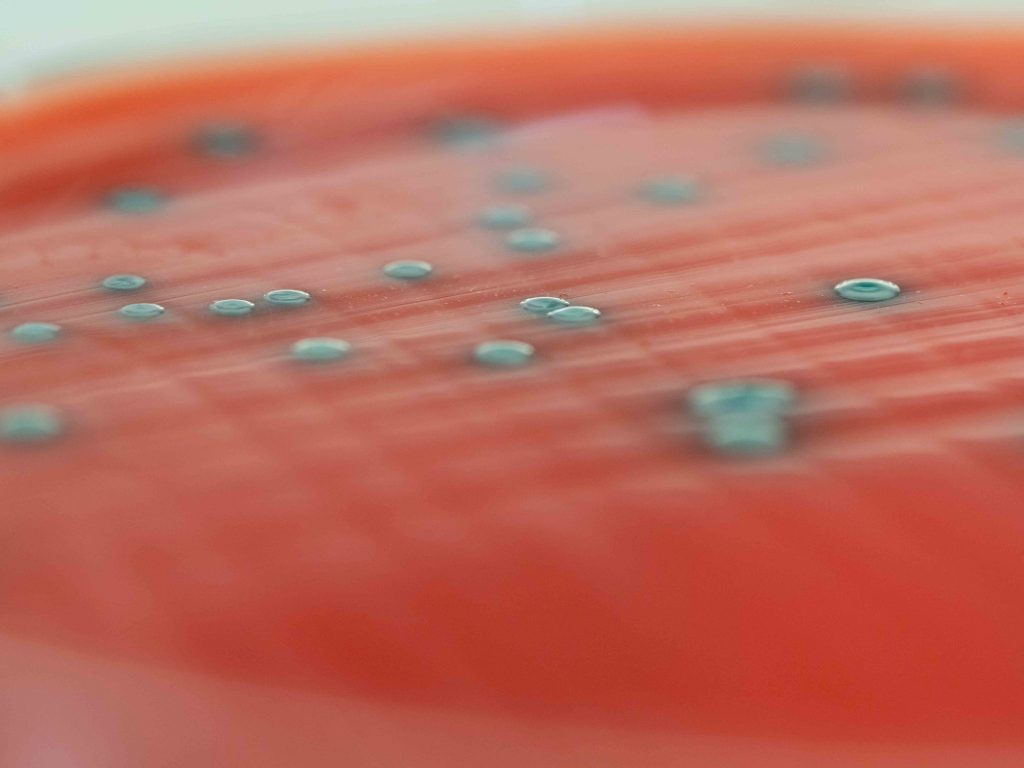
Autocontrôles microbiologiques vérification PM hygiène alimentaire QUALYSE

français
Garantir la sécurité et la qualité microbiologique des aliments
Face aux exigences réglementaires croissantes et aux enjeux sanitaires majeurs, QUALYSE met à disposition son expertise en analyses microbiologiques, sécurité alimentaire et qualité des aliments. Nous accompagnons les professionnels de l’agroalimentaire, de la restauration et des filières associées à chaque étape de la définition des besoins analytiques à l’interprétation scientifique des résultats. Nous nous appuyons sur des méthodes analytiques éprouvées, des outils de pointe et une connaissance approfondie des normes en vigueur.


Les expertises QUALYSE
en analyses microbiologiques, sécurité alimentaire, qualité des aliments


Conseil et assistance à la décision


Accompagnement opérationnel


Analyses microbiologiques


Tests spécifiques

Autocontrôles microbiologiques pour vérifier son PM


Identification et authentification




